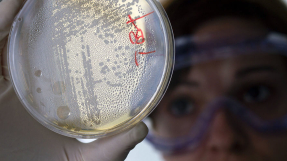

Life

Video of Catholic priest riding hoverboard during Mass goes viral
A diocese has criticised one of its priests for riding a hoverboard at the end of Mass.

Five things no one tells you about getting engaged
Phoebe Thompson shares what she's learned since getting engaged. (Hint: It's ok to panic a bit.)

Windows 10 mobile update delayed to early 2016
Recently, Microsoft announced the news regarding the release of the Windows 10 update for mobile platforms.

MediaTek Helio X20 benchmark results reveal impressive scores
The MediaTek Helio X20 did not receive much attention compared to Qualcomm's Snapdragon 820, but the test results show that the deca-core processor is an impressive chipset.
'Super-gonorrhea': Sexually transmitted disease harder to treat now as some strains resist drugs â U.K. health expert
A British health expert has issued a warning about the rise of a more powerful strain of what is being described as "super-gonorrhea," which may render this disease incurable in the future.

'Fallout 4' holiday mods: Santa Claus beats down bad guys in new video
"Fallout 4" is just one of the games that received a holiday theme just in time for the real-world holidays.

Over 2,400 babies in Brazil suspected to have brain damage due to mosquito-borne virus that came from monkeys
More than 2,400 infants in Brazil are currently being monitored for suspected brain damage, and Brazilian health officials suspect that this alarming medical situation was caused by a mosquito-borne virus transmitted from monkeys to human beings.

A menace deadlier than guns: Workplace exposure to toxic substances killing more Americans
Unbeknownst to many, there is a less publicized, but deadlier menace claiming the lives of more Americans annually: exposure to toxic substances in the workplace.

Freak Christmastime floods, tornadoes wreak havoc in southern, central U.S., killing at least 41
Floods and tornadoes that started on Christmas Day have already killed at least 41 people in southern and central U.S. states, destroying buildings and snarling vehicular traffic during a busy holiday travelling season, officials said.

'Hello, is this planet Earth?': British astronaut dials wrong number from space
British astronaut Tim Peake shared on his Twitter account that he was trying to call his home from the International Space Station when he realized he dialed the wrong number.

Pope Francis shows his healing power once again: New Jersey girl, 12, now cancer-free after he kissed her
Pope Francis did it again. The head of the Roman Catholic Church just gave a 12-year-old girl from New Jersey, U.S.A. the best Christmas gift ever that anyone can receiveâthe gift of healing.

Christmas 'miracle': Virgin Mary's image 'appears' on church window in Georgia
A silhouette image of what many believers say looked like that of the Virgin Mary appeared on a portion of glass at a Catholic church days before Christmas in the U.S. state of Georgia, drawing crowds of curious onlookers, CBS News reported.

'Just Cause 3' patch update released: Crash issue fixed, memory management improved
Patch 1.02 was rolled out last week, but some of the issues have not been fixed, especially the part wherein the game crashes when players exit to their desktop.

Samsung Galaxy A9 news: Specs, features, and release date revealed
The new entry to the Galaxy A series carries a powerful, non-removable 4,000 mAh battery.

Gay CofE priest says decision to ban him may encourage people to 'think again'
The Church of Engand priest banned from taking services after he married his partner last year has said he has no need to be angry, because so many people are angry on his behalf.

NASA's radar images of Christmas Eve asteroid show object 3,600 feet in length
The National Aeronautics and Space Administration (NASA) released a holiday gift for space scientists and enthusiasts: radar images of the asteroid that made its closest approach to Earth on Christmas Eve.